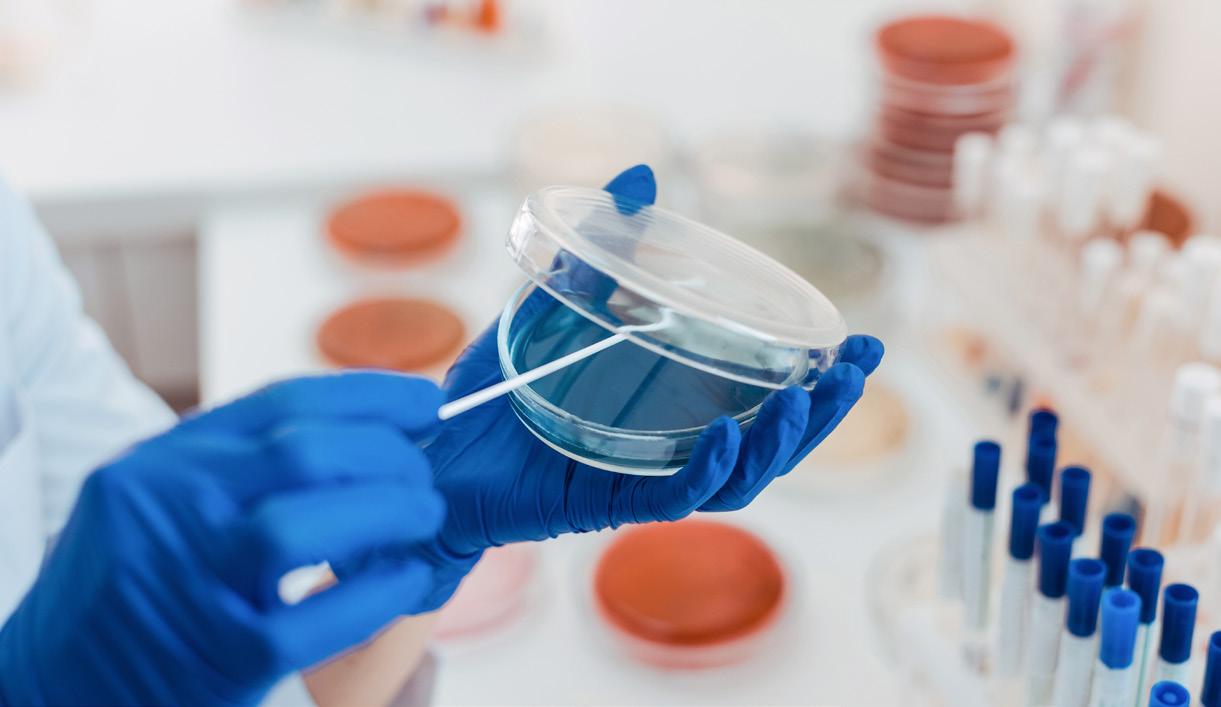

Product Catalog





As part of our mission to Make Life Better for individuals all around the globe, Unicity develops innovative nutritional products that make healthy living doable so people everywhere can enjoy a beautiful, healthy, fulfilling life.


We are committed to combating the metabolic health crisis and developing products that are obsessively backed by science, developed with integrity, and produced with the highest quality and manufacturing standards.

Science is at the core of everything we do. Unicity’s research and development team is constantly in pursuit of the better—working to discover new compounds, innovative ingredients, and to develop products that will improve human health. Unicity has recruited top scientists from around the world to be the driving force of our elite science team. Each scientist brings unique expertise and experience to Unicity and supports our ever-growing research and development initiatives.
From raw materials to finished goods, quality is built into our products. We work hard to build solid relationships with our ingredient suppliers and enact strict quality control measures to be sure we can stand behind our products, as well as provide a consistent product experience. We test our products on many levels to ensure we meet our high standards and provide a consistent and quality product. With NSF, cGMP, TGA, Kosher, Halal, and ISO-9001 certifications, we’re not the only ones who think we’re doing it right.
Many consumer-goods brands focus on developing a brand, and then outsource the bulk of their business to contractors. Unicity does things differently. We believe in overseeing everything from start to finish. That’s why we’ve invested hundreds of millions of dollars in our product development capabilities, from facilities and equipment to testing methods to highly qualified personnel.
Feel Great is designed to bridge the gap between where you are and where you want to be. It makes a healthy lifestyle totally doable and enjoyable. No more guesswork, no more stress, and no more excessive meal prep.
Feel Great will help you feel fuller for longer, prolong your breaks between meals, and give your body the nutrients that it needs. It’s time for a fresh start. It’s time to feel better than you’ve felt in years. It’s time to FEEL GREAT.


The Feel Great formula is simple:
Start your day with Unimate. Take Balance once or twice a day before meals. Do not snack afterward, and wait at least 12-16 hours before restarting the cycle the following day.
Unimate and Balance work together to help you extend the time between dinner and your first meal of the following day. Time-based eating, often referred to as intermittent fasting, has been associated with numerous health benefits like:

• Healthy blood pressure
• Improved heart health
• Improved body composition
Wake up, start your day with Unimate >>> Balance before first meal >>> and/or Balance before dinner

• Offers a highly concentrated and purified yerba mate extract.
• A potent source of up to 10x the chlorogenic acid content of a cup of coffee. (Chlorogenic acid: the “get-up-and-go” compound in coffee.)
• Promotes a feeling of satiety to keep you feeling full.
• Sugar-free.
• A patented blend of fibers, nutrients, and plant compounds that aids cholesterol absorption and proper digestion.
• Designed to help you control carbohydrate intake and maintain healthy cholesterol levels.


• A tool that fights the post-meal energy spike and crash.

• An aid that helps you stay fuller for longer.
 Balance & Unimate Lemon Ginger #33693
Balance & Unimate Lemon #33692
Balance & Unimate Black #34994
Balance & Unimate Multipack #35282
Balance & Unimate Lemon Ginger #33693
Balance & Unimate Lemon #33692
Balance & Unimate Black #34994
Balance & Unimate Multipack #35282
• Those wanting to improve their overall health.
• Individuals looking to increase their fiber intake.

• People looking for a way to make intermittent fasting easier.
• Those who want to feel more energized.
Balance Serving size: 1 packet (1-2 per day)
Unimate Serving size: 1 packet (1 per day)
Retail price: $199
Member / Distributor price: $159
Yerba mate has been traditionally used to promote mental clarity, endurance, appetite control, and an improved mood. The yerba mate leaves in Unimate undergo a unique five-step processhandpicking, fire roasting, extracting, concentrating, and purifying. As a result, Unimate is a proprietary extract that boosts the benefits of yerba mate and contains up to 10 times the amount of chlorogenic acids (mood-enhancing, brain-stimulating, feel-good elements) found in a premium cup of coffee.

Yerba mate comes from a plant native to South America, where it has been consumed in community rituals for hundreds of years. Its unique blend of plant compounds—including chlorogenic acids, mate saponins, and theobromine—is known to improve mood, heighten mental clarity, and suppress the appetite.
• Individuals on a low-carb or keto-friendly diet.
• Those looking to support their focus and improve their mood.
• People who want to start their day off strong and avoid an afternoon energy crash.
• Anyone looking to boost their stamina for workouts.
Supports feelings of well-being and relaxation.
Supports healthy cognitive processes.
Helps maintain endurance and stamina.
Supports weight management efforts.
Promotes satiety.
Promotes the body’s ketone production.
Retail price: $109
Member / Distributor price: $89



Contents
Serving Size 1 packet (6.1 g)
Servings per box 30 30-day supply

Recommended use
Mix one packet with 17-24 oz. (500-700 mL) of water (add more or less to taste). Use once daily or as desired. Drink with hot or cold water.
 Lemon #33331
Lemon Ginger #33327
Citrus Mint #29408
Lemon #33331
Lemon Ginger #33327
Citrus Mint #29408
Balance is a pre-meal drink with a patented fiber matrix that includes bioactive plant compounds, polysaccharides, and micronutrients. The fiber matrix is designed to help ease some of the impact that excess carbohydrates and cholesterol can have on the body. Balance is formulated to provide critical vitamins, minerals, and soluble fibers to help curb your appetite.

Balance contains soluble fibers. Viscous, soluble fibers form a thick gel when mixed with water and as they move through the digestive tract. The gellike substance helps slow the emptying of your stomach, which results in prolonged satiety. Balance is an excellent source of nine essential vitamins and minerals, including vitamin C and vitamin B12. The vitamins and minerals promote proper digestion, optimize the conversion of food to fuel, and support healthy metabolism.
• Adults looking to increase their fiber intake.
• Adults interested in maintaining healthy blood sugar and cholesterol levels.
• Those looking to support their weight-management efforts.
Helps curb appetite between meals.
Helps mitigate a post meal energy crash.
Promotes healthy blood glucose, insulin, cholesterol, and triglyceride levels.
Provides a great source of prebiotic fibers.
Supports a limited impact of carbohydrate intake.

Retail price: $135
Member / Distributor price: $95
#26550 Contents
Serving Size 1 packet (7.25 g)
Servings per box 60 30-day supply
For best results, take twice daily, 10-15 minutes before your two largest meals. Mix each packet with 8-10 oz. (240-300 mL) of water. Mix vigorously in a shaker cup. Drink immediately.
Most people have heard the phrase, “Take care of your body and it will take care of you.” But in today’s busy world, we don’t always get to eat the right foods with the right balance of nutrients to keep everything moving and functioning as it should, which leads to buildup of metabolic waste. Plus, the products we use every day, and even our environment, can cause harmful buildup over time.
Fortunately, our bodies are designed to eliminate waste material before it accumulates and causes health concerns. The liver, kidneys, and colon work together to ensure these harmful compounds don’t make it into the bloodstream. But when these systems aren’t working properly, it can cause fatigue and weight gain, among
other potential issues. Sometimes it’s necessary to give our bodies a little extra help to keep things moving properly through the digestive system.
Unicity Cleanse is a powerful, 30-day system that helps to first cleanse the digestive system and then nourish a healthy microbiome. It helps the body clear the digestive tract, supports the replacement of good bacteria, and then nourishes the good bacteria with prebiotic ingredients— allowing a healthy microbiome to flourish.

Gently nourishes and cleanses the digestive system.

Aids the body in eliminating toxins and waste.
Helps promote digestive regularity.
Supports a healthy microbiome.
• Individuals who want to cleanse their bodies of waste and toxins.
Increases satiety to curb appetite.
Promotes overall digestive health.
• People looking to support their gastrointestinal system.
• Those who experience occasional constipation.
• People who want to increase their fiber intake.
• Individuals wanting to maintain normal, healthy blood cholesterol and glucose levels.
• Individuals wanting to bring a healthy balance to their intestinal biome.
Unicity Cleanse comes with Paraway Plus, LiFiber, and your choice of either Nature’s Tea or Aloe Vera.

Unicity Paraway Plus is comprehensive gastrointestinal support designed to bring your microbiome into balance, aid the body in the cleansing of unwanted materials, and help protect the digestive tract. Paraway Plus’ exclusive herbal blend aids in supporting a healthy, balanced gut biome.

LiFiber is a high-quality psyllium husk product that contains dietary fiber and a proprietary herbal blend that promotes gastrointestinal health. The herbal blend gently nourishes the digestive system, helping it maintain proper function over time and promote regularity. LiFiber also provides a plant-based source of fiber that most people lack in their diets, which helps move waste through the digestive tract and helps support an overall healthy microbiome.

With senna leaf and buckthorn bark, Unicity
Nature’s Tea is formulated to act as an effective herbal intestinal cleanser to help with regularity and support your digestive system functioning properly. Its unique blend of herbs helps provide relief from occasional constipation and aids in cleansing the digestive tract.
Unicity Aloe Vera provides a powerful, natural way to gently cleanse your intestines to promote a normal healthy digestive system. It helps give your body the deep cleanse it needs to support digestive regularity and eliminate waste.

Retail price: $139
Member / Distributor price: $99
#26557 (Aloe) | #26556 (Nature’s Tea)
Recommended use
Each box contains a booklet that covers how to take each product included in the Cleanse Pack.


Always be ready for your next Unicity product with these convenient and budget-friendly accessories. Whether your goal is to stay hydrated or to take Unicity products regularly, these bottles and mixers make on-the-go nutrition easy.
Easily mix your favorite products for smooth, delicious drinks. 14 oz / 420 ml
Retail price: $14
Member / Distributor Price: $10
#26442

Drink your Unicity products in style! Whisk included to ensure drinks are smooth and well mixed every time. 17 oz / 500 ml


Retail price: $12
Member / Distributor price: $8
#32015
Powerful blending action and easy clean-up, in a portable size that’s convenient to use.
Retail price: $9
Member / Distributor price: $5
#24418

We all want to look our best, feel our best, and perform at our best. Unicity’s anti-aging products support us as we age so we can live our best life for as long as possible.
Vision Essentials Plus is formulated to help support the eyes’ natural defense mechanisms with a proven blend of potent antioxidants—bilberry, vitamin A, C, and E— and carotenoids—lutein, zeaxanthin, and astaxanthin. Together, this unique blend promotes the body’s natural ability to support macular pigment optical density (which acts as an optical filter against blue light), helps reduce eye fatigue, and supports overall vision health.

• Helps maintain the body’s macular pigment optical density, which acts as a filter against blue light.
• Helps promote antioxidant activity that can reduce eye fatigue and maintain eye integrity.
• Can help support contrast sensitivity and visual acuity.
• Adults looking for general eye health support.
• Individuals experiencing eye fatigue and strain.
• People who interact with artificial light and digital screens.
Retail price: $55
Member / Distributor price: $42
#34316
Recommended use
Take 2 softgels per day with water.
A refreshing, berry-flavored beverage formulated with hyaluronic acid, potent antioxidants, and marine collagen. It is designed to hydrate thirsty skin and help protect it from external aggressors—and it does all this from the inside out.

Retail price: $64
Member / Distributor price: $49
#33594
Enjuvenate SC was formulated to support your body and mind as you strive to meet the rigorous demands of daily life—so you can live the life you want to live.

Retail price: $156
Member / Distributor price: $120
#29440
One of the best things you can do for your skin health and energy levels is sleep more. Shoot for at least 7 hours of quality sleep each night.
Unicity Melatonin supplements the body’s melatonin production to help you get your sleep schedule back on track. Fall asleep faster and get better quality sleep.

Retail price: $30
Member / Distributor price: $24
#24785
Our bones and joints are living tissues that give our bodies shape, store crucial minerals, and allow us to move freely. Supporting our bones and joints is more than a simple healthy habit. It’s an important—and underrated—way to maximize our quality of life and ensure we have the strength and mobility to keep doing the things we love.
Bone Fortify offers a multi-tiered approach to bone health, giving your bones the best support possible. Containing calcium, vitamin D, vitamin K, and magnesium, Bone Fortify is a delicious drink mix specially formulated to support overall bone health.
• Supports overall bone health.
• Helps support the natural process involved in calcium and magnesium utilization in the body.
• Helps support the important collagen process.

• Optimizes distribution and absorption of certain vitamins and minerals.
• Adults of all ages looking to support overall bone health.
• Those looking for a multifunctional bone-health supplement that offers more than a standard calcium-only supplement.
• Adults wanting to maintain an active lifestyle.
Retail price: $42
Member / Distributor price: $32
#27395
SERVING SIZE 1 scoop (7g)
SERVINGS PER CANISTER 30
• Scoop included in canister
Recommended use
Add one scoop to 8 oz (240 mL) of water and mix well. For best results, take with your evening meal.
SELLER!The human body contains 206 bones and 360 joints. Bone mass reaches maximum density in our late 20s and early 30s, after which our bones start to weaken, making bone and joint health as we age vitally important.
Joint Mobility contains a powerful blend of ingredients—undenatured collagen type II, vitamin D, turmeric, and boswellia extract—to keep your joints healthy and strong so you can keep moving.


Retail price: $55
Member / Distributor price: $42
#27739
One of life’s most enjoyable activities—eating—loses a lot of its appeal when your digestive system isn’t working as it should. Digestive issues tend to affect more than just your stomach, too, which can be a real downer on your quality of life. Unicity has several products that make it easier to support digestive health.
With a proprietary blend of the best herbal ingredients recognized for their cleansing properties, Paraway Plus is a unique and comprehensive product designed to help your body eliminate unwanted organisms.

Retail price: $59
Member / Distributor price: $42
#26559
Unicity Nature’s Tea promotes digestive health with a natural, gentle approach. A proprietary blend of herbs provides relief from periodic constipation, aids in cleansing the digestive tract, and may reduce bloating.

Retail price: $32
Member / Distributor price: $24
#26560
Most people don’t get enough fiber from their diets, even if they eat fruits and vegetables every day. Most processed foods are stripped of fiber, and even the fruits and vegetables we buy at the store have less fiber than they used to because of modern farming methods that produce sweeter, starchier products.
Fiber is an important part of any diet, as it can help maintain normal and healthy cholesterol and glucose levels and promote the movement of materials through the digestive system. LiFiber is a plant-based source of fiber that helps support an overall healthy microbiome.

Retail price: $55
Member / Distributor price: $39
#26562
• Helps eliminate waste from the digestive system.
• Helps sustain normal, healthy blood cholesterol levels.
• Helps support a healthy digestive tract and maintain gut health.
• Helps increase satiety to curb appetite.
• Individuals who want to keep their intestinal system working properly.
• People who want to increase their fiber intake.
• Individuals wanting to maintain normal, healthy blood cholesterol and glucose levels.
• Those looking to support their overall health.
Contents
SERVING SIZE 1 level scoop (10g)
SERVINGS PER CANISTER About 45
• Scoop included in canister
Mix one level scoop of LiFiber with 8–10 oz. water. Drink immediately. Take 1–2 times daily.
Enzygen Plus combines a proprietary enzyme blend to aid in the breakdown of fats, carbohydrates, and protein, along with promoting proper digestion. It also contains a special blend of blue green algae and CereCalase—another proprietary enzyme blend.


Retail price: $45
Member / Distributor price: $32
#31940
The center of our well-being lies in the gut! A healthy intestinal flora in balance is crucial for our health, as it not only supports the health of our digestive system, but also influences many other metabolic processes including the immune system.
Retail price: $53
Member / Distributor price: $42
#29449
Water plays an important role in digestion. It helps to break down the food in your stomach, helps move food through the digestive system, flushes out toxins, and helps keep your bowel movements regular.
Super Green + is a drink mix with a blend of high-quality plant phytonutrients and niacin, designed to support healthy inflammation, immune system health, and digestive system functionality.

Retail price: $31
Member / Distributor price: $24
#34637
• Helps promote digestive regularity.
• Supports the gastrointestinal system.

• Helps cleanse the digestive tract.
• Supports the body’s natural elimination process.
Ideal for
• Those looking for a gentle way to help cleanse the digestive system.
• Individuals who experience occasional constipation.
• People wanting to support their gastrointestinal health.
With great healing, antimicrobial, and laxative qualities, Aloe Vera helps gently cleanse the colon and intestines. It’s also a good source of vitamins and minerals, which helps to sustain gastrointestinal health.
Retail price: $30
Member / Distributor price: $24
#26561
Contents
SERVING SIZE 1 capsule
SERVINGS PER PACKAGE 50
Recommended use
Take 1 capsule by mouth daily with water.
• Formulated to help support healthy glucose and cholesterol levels.
• Supports cardiovascular, digestive, and metabolic health.

• Helps curb appetite.
Ideal for
• Individuals wanting to maintain healthy cholesterol and glucose levels.
• Those looking for a healthy way to help curb appetite.
• Adults wanting to increase their fiber intake.
Bios Life 2 has been clinically proven to lower cholesterol. It provides essential fiber and other nutrients to support your cardiovascular and digestive health, curb your appetite, and promote healthy blood glucose levels. Substances like glucose and cholesterol are necessary for your body to function properly, but you want to maintain healthy levels. Bios Life 2® can help you with that. It’s formulated to help your body regulate and keep your glucose and cholesterol levels where they should be.
Retail price: $95
Member / Distributor price: $72
#28836 Contents
SERVING SIZE 1 scoop (6 g)
SERVINGS PER CANISTER About 63
• Scoop included in canister
Recommended use
Mix 1 rounded scoop with 8 to 10 ounces of cold water. Mix vigorously and drink immediately. Take 5 to 10 minutes before your largest meals, up to 3 times daily.
Good heart health is essential for maintaining overall health. A healthy heart supports circulation, increases energy levels, and helps keep blood pressure where it should be, all of which help to improve your quality of life.
CoQ10 supports cardiovascular health by replenishing the body’s supply of coenzyme Q10, which declines as we age. CoQ10 is known for its ability to facilitate energy conversion and support antioxidant activity in the body.


Retail price: $46
Member / Distributor price: $32
#33598
OmegaLife-3 Resolv is a high-quality, concentrated, purified fish-oil supplement that delivers two of the most powerful omega-3 fatty acids, EPA and DHA.

Retail price: $59
Member / Distributor price: $42
#30400
Your immune system is like your personal bodyguard. It works hard, day in and day out, to protect you from harmful invaders, helping with everything from avoiding illnesses to recovering from injury.
Bio-C
Vitamin C supports many bodily functions, including heart, eye, skin, and immune functions. Bio-C is a powerful vitamin C complex that combines concentrated antioxidants with citrus bioflavonoids, which promote prolonged vitamin C absorption in the body.

Retail price: $39
Member / Distributor price: $32
#0954
Combining noni fruit with essential vitamins and minerals has led to Unicity Hawaiian Noni, a unique blend that promotes both immune and gut health—and tastes like a day at the beach.

Retail price: $77
Member / Distributor price: $59
#30350
The immune system is constantly adapting and changing in order to protect your body against new threats. It knows how to protect you more than just about anything else because of its ability to personalize your immune protection.
To meet life’s daily demands, the immune system needs to be at its best. Immunizen contains a proprietary blend of ingredients that supports the body’s natural immune functions, promotes friendly intestinal bacteria, and provides the body with beneficial antioxidants.

• Promotes a normal, healthy immune response.
• Promotes the growth and activity of beneficial bacteria.
• Supports the innate, passive, and adaptive immune responses.
• Supports overall health and well-being.
• Adults who want to support their immune health.
• Individuals who want to support the body’s natural immune defense system.
Retail price: $55
Member / Distributor price: $42
#18401 Contents
SERVING SIZE 2 capsules SERVINGS PER CONTAINER 30
Recommended use
Take 2 capsules once daily, with water. For additional support, take up to 6 capsules daily for 10 days as needed.
Weight management can be tricky without the right support. Unicity products align with your weight-management efforts while providing essential nutrition and energy support.
There’s nothing quite like a good workout—and Quadplex can help ensure your next workout is as good as your last. Quadplex is full of ingredients that will help your body stay strong and help refuel your muscles, including 25 grams of whey protein and 15 vitamins and minerals.

Retail price: $79
Member / Distributor price: $59
#29612
Packed with high-quality whey protein, fiber, and essential vitamins and minerals, Unicity Complete Vegan helps you maintain balanced nutrition without the hassle of meal prep.

Retail price: $99
Member / Distributor price: $72
#27587
You know you want to eat healthier and feel better, but you also know that it’s sometimes easier said than done. You need to make sure you’re controlling your caloric intake, getting enough protein, and eating foods that won’t make your blood glucose spike, all while getting the right nutrients. Unicity Complete is a convenient way to meet all these needs—plus, it’s delicious and filling!
• High-quality protein and fiber provide energy without insulin spikes.

• A nutritious meal replacement.
• Promotes feelings of satiety.
• 20 grams of high-quality protein per serving.
Ideal for
• Individuals looking for a nutritious meal replacement.
• Those who want to get more essential vitamins and minerals in their diet.
• People seeking low-carb, keto-friendly and low-fat protein options.
• Individuals who want to support metabolic health and body composition.
Chocolate Vanilla
Retail price: $99
Member / Distributor price: $72
#29694 (Vanilla) | #27585 (Chocolate)


Contents
SERVING SIZE 2 scoop (37g)
SERVINGS PER CANISTER 30
• Scoop included in canister
Recommended use
Mix two scoops of Complete with water or milk. Stir or shake well and drink immediately. Enjoy the shake once a day.
The right mindset is all too often the missing ingredient holding us back from completing projects and staying focused on important tasks. Sometimes all we need is a little extra oomph to stay positive and help us cross that finish line.
Your life’s ambitions should not be inhibited by physical fatigue or mental exhaustion. Unicity Matcha aims to energize your body and mind, giving you the vitality and clarity you need to fully experience life. This carefully selected, ceremonial-grade Japanese Chi-Oka Matcha is rich in antioxidants and other vital nutrients.

Retail price: $110
Member / Distributor price: $82
#32628
BioReishi FX is formulated with reishi mushrooms and coconut creamer to provide sustained, no-sugaradded energy. This multidimensional brew supports immune health and tastes delicious, too.

Retail price: $42
Member / Distributor price: $32
#35228
• Provides your mind with a boost of mental clarity and your body with a boost of energy.
• Unique blend of L-theanine, citicoline, B vitamins, and L-carnitine work to optimize physical and mental performance.
• Synergistic effect of L-theanine with caffeine helps you stay energized and productive without the sugar crash or jittery effects common in most energy drinks.
• Supports antioxidant activity by cleansing the body of impurities and helping to process nutrients.
• Anyone who wants to support mental clarity.
• People who want a healthy pre-workout drink.
• Individuals looking for ceremonial-grade matcha.
• Those wanting a physical energy boost without the jittery effects of coffee and energy drinks.
Your life’s ambitions should not be inhibited by physical fatigue or mental exhaustion. Unicity Matcha Energy aims to energize your body and mind, giving you the vitality and clarity you need to fully experience life. This carefully selected, ceremonial-grade Japanese Chi-Oka Matcha is rich in antioxidants and other vital nutrients. It is formulated to increase energy and mental concentration, as well as burn fat.

Retail price: $119
Member / Distributor price: $82
#26552 Contents
Recommended use
Mix contents of 1 Matcha packet into 8-10 ounces of water. For a delicious refreshment, try adding ice to your Unicity Matcha. Mix thoroughly and enjoy!


Unimate Fuel Natural combines Unicity’s potent yerba mate extract with medium chain triglycerides (MCTs) from coconut oil to provide an energy boost for both body and mind. Unimate Fuel Natural is a great way to start your day, fend off cravings, and reenergize between meals.
Retail price: $109
Member / Distributor price: $89
#32025
Yerba mate, the hero ingredient in Unimate Fuel, is known for its ability to promote mental clarity, endurance, appetite control, and an improved mood. Add a delicious salted caramel flavor and you have a unique beverage you’ll want to enjoy again and again.
Retail price: $109
Member / Distributor price: $89
#32021
L-theanine, an ingredient commonly found in matcha, has calming effects, which helps support focus, sleep quality, cognitive function, and relaxation. This is how matcha is able to energize you without making you feel jittery.

Unicity corporate headquarters
Phone: 1-801-226-2600
Mail: 1712 South East Bay Blvd Suite 101 Provo, UT 84606
Website: www.unicity.com
Customer support
Phone: 1-800-UNICITY (864-2489)
Fax: 1-800-226-6232
Email: cs@unicity.com ©2023